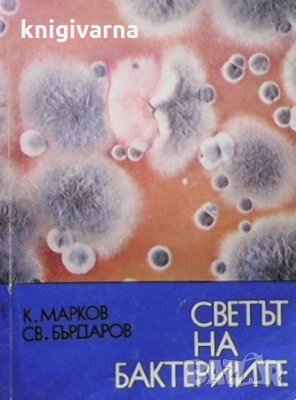
Светът на бактериите Светослав Бърдаров, снимка 1

Варна Марко Балабанов 49
В Bazar.BG от 01 септември 2015г.
Последно активен
днес в 06:20 ч.
Светът на бактериите Светослав Бърдаров → Обява 35773347
Светът на бактериите Светослав Бърдаров
състояние:
Много добро-Дребни забележки.
издателство:
Медицина и физкултура
град на издаване:
София
година на издаване:
1975
език:
Български
страници:
81
корици:
меки
формат:
195/140мм
книгата е в наличност
к-96-2820504
Светът на бактериите
Светослав Бърдаров, Калчо Марков
Преглеждания: 305
Другите търсят също
Вход
Регистрация
Влез в профила си или се регистрирай, за да не губиш наблюдаваните обяви, търсенията си и следваните потребители – ще ги имаш навсякъде с теб.
Вход/Регистрация